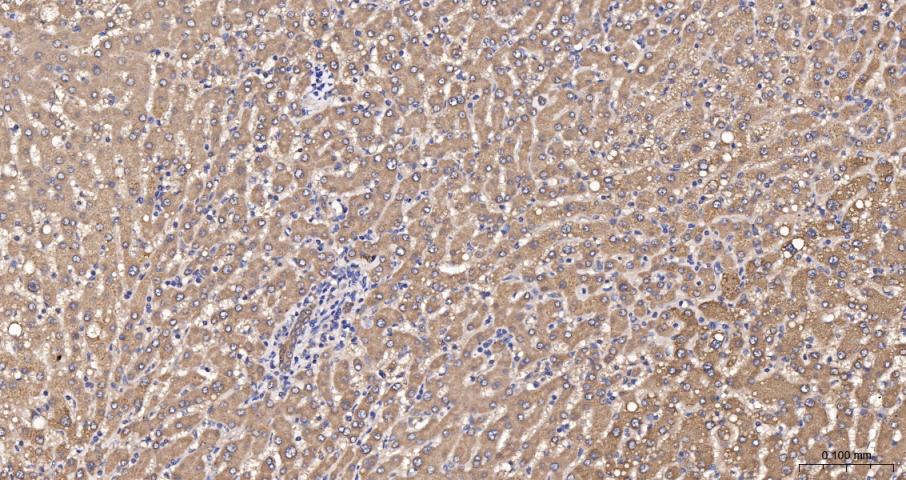
产品细节图片13
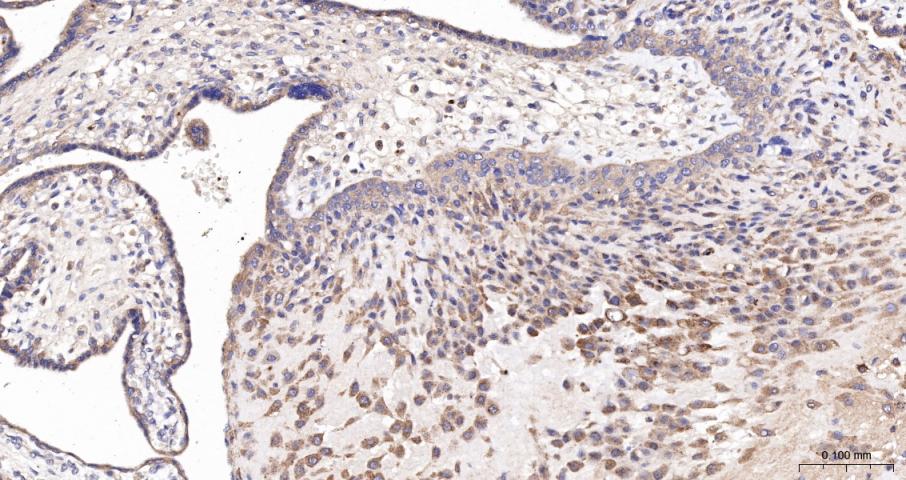
产品细节图片16

相关产品推荐更多 >

TOB Rabbit pAb, FITC conjugated(bs-18164R-FITC)-100ul
¥2980
Anti-human TNFRSF10B / TRAILR2 / CD262 (Lexatumumab Biosimilar)(BIO0794SM)-1mg/5mg/20mg
¥3200
prox1 Rabbit pAb, BF647 conjugated(bs-2774R-BF647)-100ul
¥2980
CHST14 Rabbit pAb, Biotin conjugated(bs-13933R-Bio)-100ul
¥2980
LRRC53 Rabbit pAb(bs-18397R)-50ul/100ul/200ul
¥1180
万千商家帮你免费找货
0 人在求购买到急需产品
- 详细信息
- 询价记录
- 文献和实验
- 技术资料
- 应用范围:
产品信息以Bioss网站为准
- 规格:
50ul/100ul/200ul
| 规格: | 50ul | 产品价格: | ¥1180.0 |
|---|---|---|---|
| 规格: | 100ul | 产品价格: | ¥1980.0 |
| 规格: | 200ul | 产品价格: | ¥2800.0 |
| 产品编号 | bs-0611R |
| 英文名称 | ADIPOR2/PAQR2 Rabbit pAb |
| 中文名称 | 脂联素受体2抗体 |
| 英文别名 | PAQR2_HUMAN; Adiponectin receptor protein 2; Progestin and adipoQ receptor family member 2 ; Progestin and adipoQ receptor family member II; ACDCR2; |
| 产品应用 | WB=1:500-2000, IHC-P=1:100-500, IHC-F=1:100-500, IF=1:100-500, Flow-Cyt=1μg /test Not yet tested in other applications. |
| 交叉反应 | Human, Mouse, Rat (Chicken, Dog, Pig, Cow) |
| 抗体来源 | Rabbit |
| 免疫原 | KLH conjugated synthetic peptide derived from human Adiponectin receptor 2 |
| 亚型 | IgG |
| 性状 | Liquid |
| 纯化方法 | affinity purified by Protein A |
| 克隆类型 | Polyclonal |
| 理论分子量 | 44 kDa |
| 浓度 | 1mg/ml |
| 储存液 | 0.01M TBS (pH7.4) with 1% BSA, 0.02% Proclin300 and 50% Glycerol. |
| 研究领域 | Cardiovascular > Atherosclerosis > Diabetes associated Cardiovascular > Atherosclerosis > Lipoprotein metabolism Cardiovascular > Lipids / Lipoproteins > Fatty Acids > Metabolism Metabolism > Pathways and Processes > Metabolic signaling pathways > Energy transfer pathways > Energy Metabolism Metabolism > Pathways and Processes > Metabolic signaling pathways > Lipid and lipoprotein metabolism > Fatty acids Metabolism > Pathways and Processes > Metabolic signaling pathways > Lipid and lipoprotein metabolism > Lipoprotein metabolism Metabolism > Pathways and Processes > Redox metabolism > Fatty acid oxidation Metabolism > Types of disease > Cancer Metabolism > Types of disease > Diabetes Metabolism > Types of disease > Heart disease Signal Transduction > Growth Factors/Hormones > Hormones Signal Transduction > Metabolism > Energy Metabolism Signal Transduction > Metabolism > Lipid metabolism |
| 亚基 | May form homo and heteromultimers. |
| 亚细胞定位 | Membrane; Multi-pass membrane protein. Note=Localized to the cell membrane and intracellular organelles. |
| 组织特异性 | Highly expressed in skeletal muscle, liver and placenta. Weakly expressed in brain, heart, colon, spleen, kidney, thymus, small intestine, peripheral blood leukocytes and lung. |
| 相似性 | Belongs to the ADIPOR family. |
| 功能 | Receptor for globular and full-length adiponectin (APM1), an essential hormone secreted by adipocytes that acts as an antidiabetic. Probably involved in metabolic pathways that regulate lipid metabolism such as fatty acid oxidation. Mediates increased AMPK, PPARA ligand activity, fatty acid oxidation and glucose uptake by adiponectin. Has some intermediate-affinity receptor activity for both globular and full-length adiponectin. |
| 保存条件 | Shipped at 4℃. Store at -20℃ for one year. Avoid repeated freeze/thaw cycles. |
| 注意事项 | This product as supplied is intended for research use only, not for use in human, therapeutic or diagnostic applications. |
| 背景资料 | The adiponectin receptors, ADIPOR1 (MIM 607945) and ADIPOR2, serve as receptors for globular and full-length adiponectin (MIM 605441) and mediate increased AMPK (see MIM 602739) and PPAR-alpha (PPARA; MIM 170998) ligand activities, as well as fatty acid oxidation and glucose uptake by adiponectin (Yamauchi et al., 2003 [PubMed 12802337]).[supplied by OMIM, Mar 2008] |
| 应用 | 推荐稀释比例 |
| {WB} | {1:500-2000} |
| {IHC-P} | {1:100-500} |
| {IHC-F} | {1:100-500} |
| {IF} | {1:100-500} |
| {Flow-Cyt} | {1μg /test} |

Antigen retrieval: citrate buffer ( 0.01M, pH 6.0 ), Boiling bathing for 15min; Block endogenous peroxidase by 3% Hydrogen peroxide for 30min; Blocking buffer (normal goat serum,C-0005) at 37℃ for 20 min;
Incubation: Anti-Adiponectin Receptor 2 Polyclonal Antibody, Unconjugated(bs-0611R) 1:200, overnight at 4°C, followed by conjugation to the secondary antibody(SP-0023) and DAB(C-0010) staining

Antigen retrieval: citrate buffer ( 0.01M, pH 6.0 ), Boiling bathing for 15min; Block endogenous peroxidase by 3% Hydrogen peroxide for 30min; Blocking buffer (normal goat serum,C-0005) at 37℃ for 20 min;
Incubation: Anti-Adiponectin Receptor 2 Polyclonal Antibody, Unconjugated(bs-0611R) 1:300, overnight at 4°C, followed by conjugation to the secondary antibody(SP-0023) and DAB(C-0010) staining

Primary Antibody:Rabbit Anti-Adiponectin receptor 2 antibody (bs-0611R,Green); Dilution: 1μg in 100 μL 1X PBS containing 0.5% BSA;
Isotype Control Antibody: Rabbit IgG(orange) ,used under the same conditions;
Secondary Antibody: Goat anti-rabbit IgG-FITC(white blue), Dilution: 1:200 in 1 X PBS containing 0.5% BSA.
Protocol
The cells were fixed with 2% Paraformaldehyde for 10 min at 37℃. Primary antibody (bs-0611R, 0.2μg /1x10^6 cells) were incubated for 30 min at room temperature, followed by 1 X PBS containing 0.5% BSA + 1 0% goat serum (15 min) to block non-specific protein-protein interactions. Then the Goat Anti-rabbit IgG/FITC antibody was added into the blocking buffer mentioned above to react with the primary antibody at 1/200 dilution for 40 min at room temperature. Acquisition of 20,000 events was performed.

Lane 1: Heart (Mouse) Lysate at 40 ug
Lane 2: Skeletal muscle (Mouse) Lysate at 40 ug
Lane 3: Heart (Rat) Lysate at 40 ug
Lane 4: Skeletal muscle (Rat) Lysate at 40 ug
Lane 5: 293T (Human) Cell Lysate at 30 ug
Primary: Anti-Adiponectin receptor 2 (bs-0611R) at 1/1000 dilution
Secondary: IRDye800CW Goat Anti-Rabbit IgG at 1/20000 dilution
Predicted band size: 44 kD
Observed band size: 43 kD

风险提示:丁香通仅作为第三方平台,为商家信息发布提供平台空间。用户咨询产品时请注意保护个人信息及财产安全,合理判断,谨慎选购商品,商家和用户对交易行为负责。对于医疗器械类产品,请先查证核实企业经营资质和医疗器械产品注册证情况。
- 作者
- 内容
- 询问日期
文献和实验[IF={{ 6.43 }}] {Morad, Vivian, Annelie Abrahamsson, and Charlotta Dabrosin. "Estradiol affects extracellular leptin: adiponectin ratio in human breast tissue in vivo." The Journal of Clinical Endocrinology & Metabolism (2014).} {IHC} {="Human"}
[IF={{ 5.1 }}] {Zacharias Amanda M.. et al. Site- and cell-type-specific miRNA and mRNA genes and networks across the cortex, striatum, and hypothalamus. COMMUN BIOL. 2025 Jul;8(1):1-15} {IF} {Mouse}
[IF={{ 5.037 }}] {Annamária Schaffer. et al. The ontogenies of endometrial and myometrial leptin and adiponectin receptors in pregnant rats: Their putative impact on uterine contractility. Life Sci. 2022 May;297:120465} {WB} {Rat}
[IF={{ 4.75 }}] {Guo et al. Effect of telmisartan on the expression of adiponectin receptors and nicotinamide adenine dinucleotide phosphate oxidase in the heart and aorta in type 2 diabetic rats. (2012) Cardiovasc.Diabetol. 11:94} {IHC} {Rat}
[IF={{ 4.4 }}] {Jerad H. Dumolt. et al. Trophoblast-specific overexpression of adiponectin receptor 2 causes fetal growth restriction in pregnant mice. FASEB J. 2024 Oct;38(19):e70100} {WB} {Mouse}
= NAL), appears to form upon oxidative cyclization of the nonfluorescent 2:1 lysine-HNE Michael adduct-Schiff base cross-link (Scheme 1). Polyclonal antibody (PAb) to the NAL-HNE fluorophore was raised in rabbit and found to be highly specific
. Retrieved 2010-11-29. ^ Nielsen BS, Jørgensen S, Fog JU, Søkilde R, Christensen IJ, Hansen U, Brünner N, Baker A, Møller S, Nielsen HJ (October 2010). "High levels of microRNA-21 in the stroma of colorectal cancers predict short disease-free survival
+oieSKeKcgxGinlRPl7uja5iYeDdc+K3eZhXhIOHOy+p9cxrGU9WCTkVcT5iRR/BsR+N0IDPSu3x0pXo0IRAQiAhGBiEBE4ABCwPnwbu0wGmW8ULj7NRb20DLRYqFW1Up6ODBube+wknwaZ5w/y92bXLbV5K3CJ+hhzKwdSHCmVrada2Qy0eyxvi0r7Lkl99ukcaOkRe60Sj82E8qgnmxNtzHGRRyZQtf1g41GIMau5W7ITlqbiDRR0CA3tPhIsEdmP5hZ
技术资料暂无技术资料 索取技术资料






